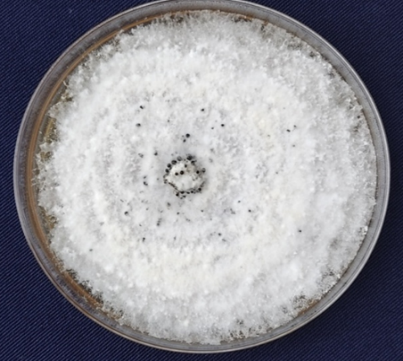
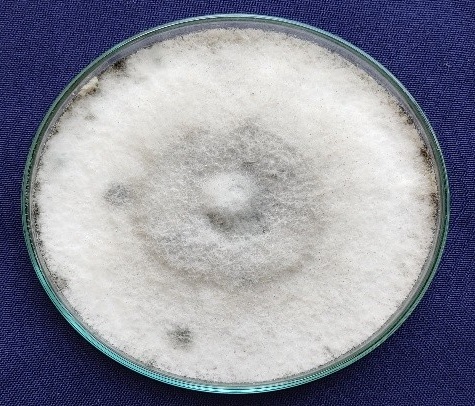
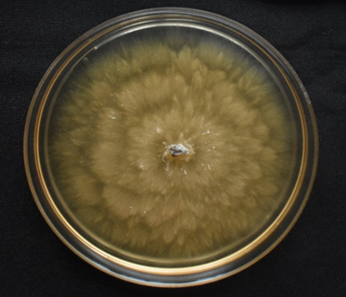

Projects
- Characterization and synthesis of female sex pheromone of Tea Mosquito Bug; (Helopeltis antonii) and its bioassay (10/2020-09/2025)
Dr. T N Raviprasad, Dr. K. Vanitha & Dr. K. Subaharan - Assessing the field effectiveness of entomopathogenic nematodes (EPN) and indigenous strain of entomopathogenic fungus (EPF) in management of cashew stem and root borers (Plocaederus ferrugineus and Plocaederus obesus) (09/2021-08/2026)
Dr. T N Raviprasad, Dr. K. Vanitha & Dr. Rajkumar - Species complex of thrips infesting cashew, their role and management measures (09/2022-09/2025)
Dr. K. Vanitha, Dr. Rachana, R.R., Dr. T.N. Raviprasad, Dr. Rajashekara, H & Dr. Mohana G.S. - Development of an eco-friendly and cost-effective pest management strategy for cashew using plant and microbial-based pesticides (09/2024-09/2028)
Dr. K. Vanitha, Dr. T.N. Raviprasad, Dr. K. Velmourougane, Dr. A. Kandan, and Dr. Rajashekara, H - Survey and diagnosis of diseases occurring in cashew through morphological and molecular characterisation and their management (09/2021-08/2027)
Dr. H. Rajashekara, Dr. T.N. Raviprasad, Dr. Siddanna Savadi & Dr. RTP Pandian - Deciphering the role of core floral microbiome in enhancing productivity in cashew (10/2024-08/2027)
Dr. H. Rajashekara, Dr. Vanitha K & Dr. Veena G.L.
Externally funded projects
- RKVY Project: Establishment of farmer-centric pest diagnostic and bio-control laboratory to achieve sustainable cashew health management (04/2022 – 03/2024)
Dr. Rajashekara H., Dr. Vanitha. K, Dr. T.N. Raviprasad & Dr. Siddanna Savadi - RKVY Project: Establishment of state-of-the-art facilities for chemical ecology studies targeting eco-friendly pest management and demonstration in cashew (05/2024-05/2026)
Dr. Vanitha K., Dr. T.N. Raviprasad, Dr. Veena G.L., Dr. H. Rajashekara, Dr. Thondaiman V & Dr. Babli Mog
Salient Achievements
- Standardized laboratory rearing methodologies for the following insects and natural enemies
- Tea mosquito bug (Helopeltis spp.) on cashew shoots
- Cashew stem and root borer (Plocaederus spp.) on cashew bark
- Cashew stem and root borer (Plocaederus spp.) on semi-synthetic diet
- Reduviid bug species using wax moth larvae as prey
- Praying mantid species using wax moth larvae as prey
- Varietal resistance
A mid-season flowering variety which escapes TMB damage during peak flowering and produces flowers after TMB infestation has been identified and released as ‘Bhaskara’ - Documentation of insect pests and pollinators
More than 150 insect pests infesting cashew, their natural enemies and the pollinators have been documented; and the biology of major insects, natural enemies and solitary bees was studied. - Technologies
- Semi-synthetic diet for cashew stem and root borer
- IPM strategies for TMB
- IPM strategies for cashew stem and root borer
- Artificial bee nests for Braunsapis spp.
- Other accomplishments
Cashew pest database – a website giving information on various cashew pests
Website on Beneficial arthropods in cashew plantations
Bee conservation park for the conservation of pollinators.
- Standardized laboratory rearing methodologies for the following insects and natural enemies
Plant Pathology
- The Cashew Leaf Blight (CLB) disease caused by Neopestalotiopsis clavispora in nursery conditions with 25-30% disease incidence, was reported. The disease symptomology, cultural and morphological characterisation of the pathogen and multigene analysis for identification of the pathogen up to the species level were documented

- The Cashew Leaf Blight (CLB) disease caused by Neopestalotiopsis clavispora in nursery conditions with 25-30% disease incidence, was reported. The disease symptomology, cultural and morphological characterisation of the pathogen and multigene analysis for identification of the pathogen up to the species level were documented
- Identified propiconazole 25% EC @ 0.1% and flusilazole 12.5% + carbendazim 25% SC @ 0.2% were found effective for the management of cashew leaf blight and anthracnose disease of cashew apple
- Whole genome sequencing of Neopestalotiopsis clavispora revealed a total assembled genome size of 59.25 Mb with base pair length of 60576399, N50 contig size of 129039 bp, GC content ratio of 50.05%

- The Anthracnose disease of cashew apple caused by Colletotrichum siamens was reported. The disease symptoms, pathogen characterization using cultural, morphological and multigene approaches were documented
- The seedling rot disease of cashew caused by Beltrania rhombica in nursery conditions was reported

Infrastructure facilities
- A well-equipped pest diagnostic and biocontrol laboratory with different facilities like Thermal cycler, nanodrop, refrigerated centrifuge, a gel documentation system, laminar air flow, BOD incubators, vertical autoclave, etc., through external funding was established.


- A well-equipped pest diagnostic and biocontrol laboratory with different facilities like Thermal cycler, nanodrop, refrigerated centrifuge, a gel documentation system, laminar air flow, BOD incubators, vertical autoclave, etc., through external funding was established.
- Insect-proof net house and glasshouse facilities for artificial screening of pests and diseases were built


Scientists

Dr. T.N. Raviprasad
Principal Scientist
(Agril. Ent.)

Dr. Vanitha, K.
Senior Scientist
(Agril. Ent.)

Dr. Rajashekara, H.
Senior Scientist
(Plant Pathology)
